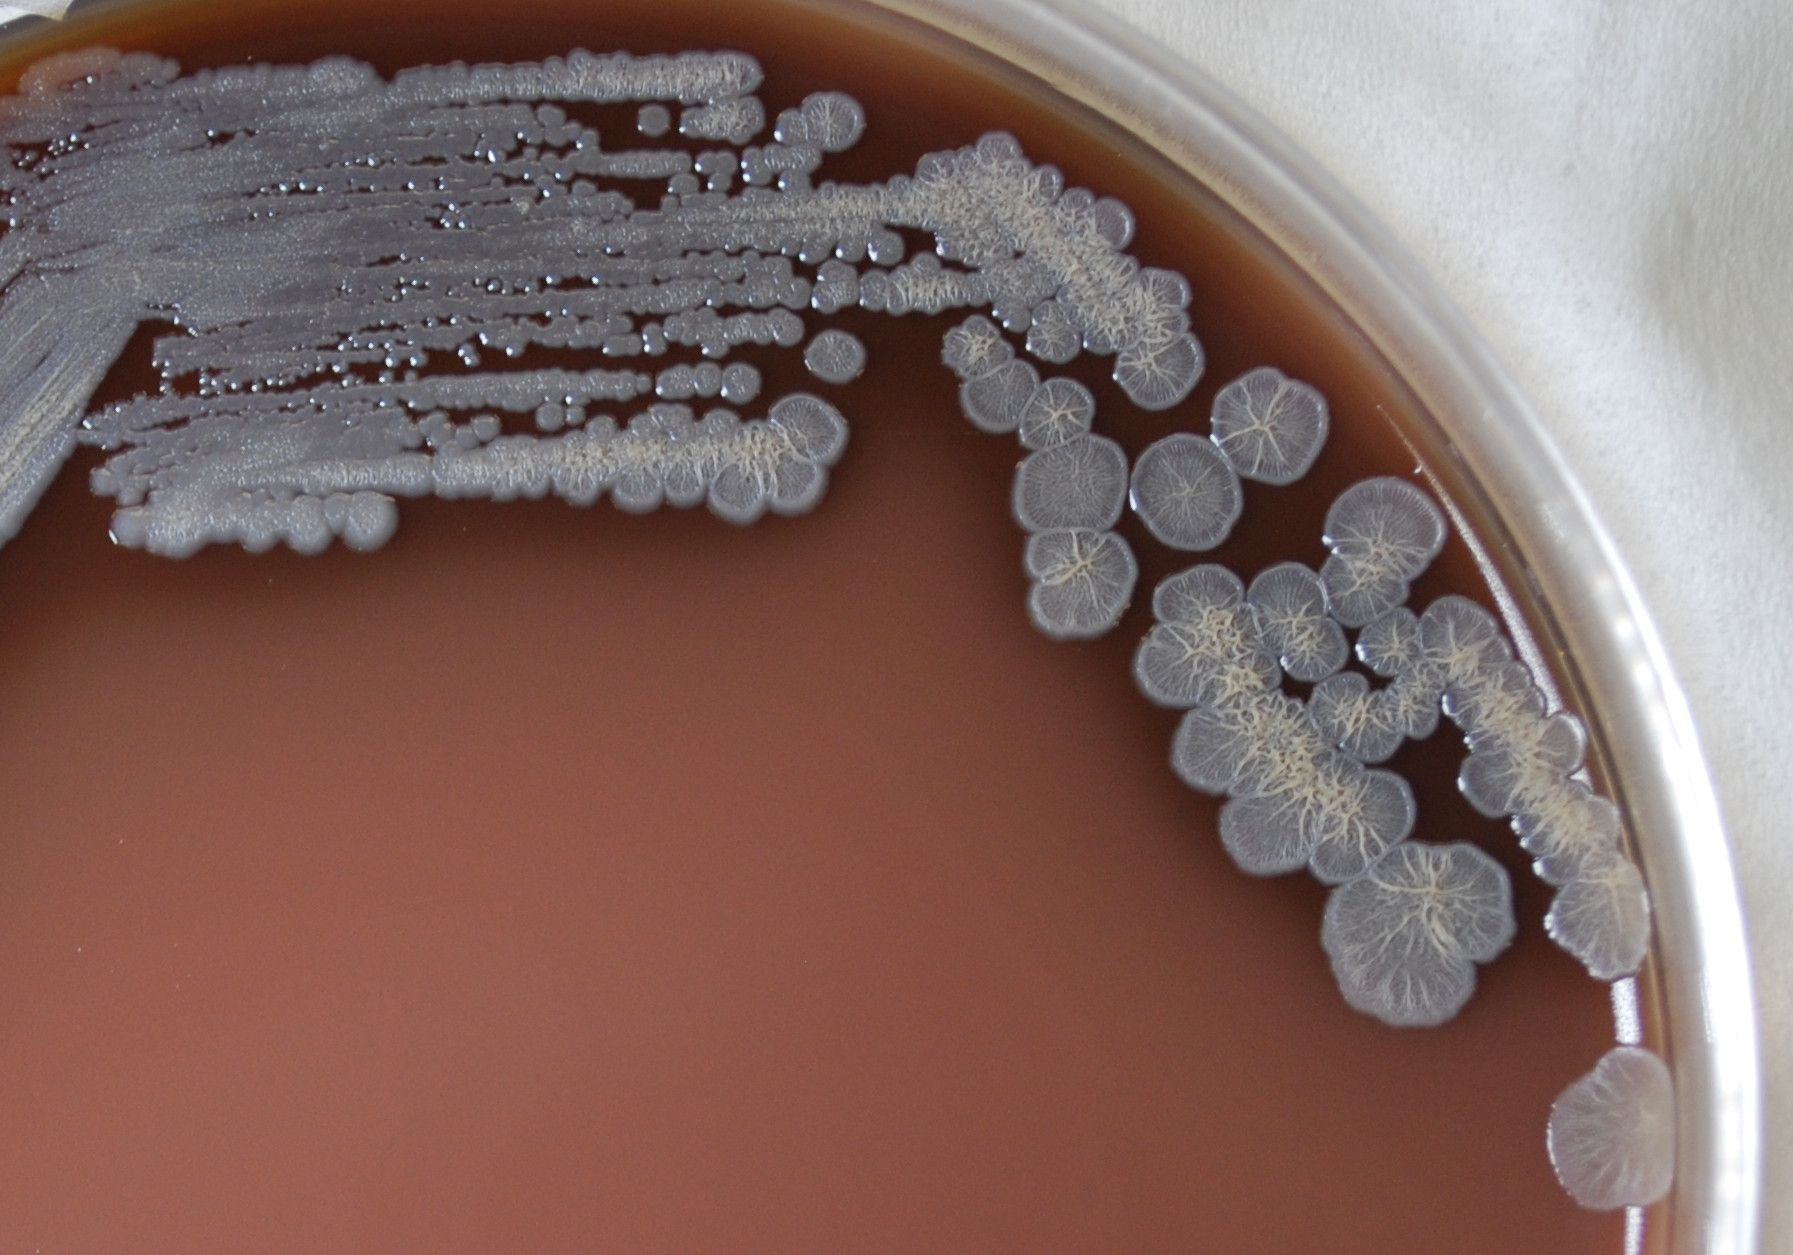

44 completely opposed crossword clue
Completely opposed - 4 answers | Crossword Clues We found 4 answers for the crossword clue Completely opposed. Are you looking for more answers, or do you have a question for other crossword enthusiasts? Use the "Crossword Q & A" community to ask for help. If you haven't solved the crossword clue Completely opposed yet try to search our Crossword Dictionary by entering the letters you already know! COMPLETELY OPPOSED crossword clue - All synonyms & answers 'COMPLETELY OPPOSED' is a 17 letter Phrase starting with C and ending with D Crossword answers for COMPLETELY OPPOSED Synonyms for DIAMETRIC 5 letter words polar 9 letter words antipodal Thanks for visiting The Crossword Solver "Completely opposed". We've listed any clues from our database that match your search for "Completely opposed".
Completely Opposed Crossword Clue and Solver - Crossword Solver The CroswodSolver.com system found 25 answers for completely opposed crossword clue. Our system collect crossword clues from most populer crossword, cryptic puzzle, quick/small crossword that found in Daily Mail, Daily Telegraph, Daily Express, Daily Mirror, Herald-Sun, The Courier-Mail, Dominion Post and many others popular newspaper.
/cloudfront-us-east-1.images.arcpublishing.com/tgam/KFCWN3DKIVFDBCJX6APOM6CNWI)
Completely opposed crossword clue
OPPOSED crossword clue - All synonyms & answers OPPOSED Crossword Clue & Answer 'OPPOSED' is a 7 letter Word starting with O and ending with D All Solutions for OPPOSED Synonyms, crossword answers and other related words for OPPOSED We hope that the following list of synonyms for the word opposed will help you to finish your crossword today. Completely opposed to being in and left (8) - Crossword Genius Completely opposed to being in and left - Crossword Clue, Answer and Explanation Menu. ... Cryptic Crossword guide; Completely opposed to being in and left (8) I believe the answer is: outright I'm a little stuck... Click here to teach me more about this clue! ' completely ' is the definition. (outright means completely or totally) I don't ... Completely opposed - crossword puzzle clues & answers - Dan Word Completely opposed. Today's crossword puzzle clue is a general knowledge one: Completely opposed. We will try to find the right answer to this particular crossword clue. Here are the possible solutions for "Completely opposed" clue. It was last seen in Daily general knowledge crossword. We have 1 possible answer in our database.
Completely opposed crossword clue. completely opposed (9) Crossword Clue | Wordplays.com completely opposed (9) Crossword Clue The Crossword Solver found 30 answers to "completely opposed (9)", 9 letters crossword clue. The Crossword Solver finds answers to classic crosswords and cryptic crossword puzzles. Enter the length or pattern for better results. Click the answer to find similar crossword clues . Enter a Crossword Clue OPPOSED Crossword Clue & Synonyms SOLVE THE CLUE Best Answers for OPPOSED 6 Letters: AVERSE COARSE CLOUDY 4 Letters: ANTI MEAN 7 Letters: AGAINST COUNTER ANTONYM 8 Letters: ACCURSED ARGUABLE CONTRARY All 194 Answers for: Opposed Synonyms for OPPOSED We found 35 Synonyms 5 Letter Word ALIEN LOATH RIVAL VYING 6 Letter Word AVERSE FACING 7 Letter Word ADVERSE COUNTER HOSTILE Completely opposed - Crossword clues & answers - Global Clue Completely opposed. Let's find possible answers to "Completely opposed" crossword clue. First of all, we will look for a few extra hints for this entry: Completely opposed. Finally, we will solve this crossword puzzle clue and get the correct word. We have 1 possible solution for this clue in our database. Opposed or completely different (8) Crossword Clue - Wordplays The Crossword Solver found 30 answers to "Opposed or completely different (8)", 8 letters crossword clue. The Crossword Solver finds answers to classic crosswords and cryptic crossword puzzles. Enter the length or pattern for better results. Click the answer to find similar crossword clues . Enter a Crossword Clue Sort by Length
Completely opposed Crossword Clue | Wordplays.com Completely opposed Crossword Clue The Crossword Solver found 30 answers to "Completely opposed", 4 letters crossword clue. The Crossword Solver finds answers to classic crosswords and cryptic crossword puzzles. Enter the length or pattern for better results. Click the answer to find similar crossword clues . Enter a Crossword Clue Sort by Length completely (opposed) Crossword Clue | Wordplays.com completely (opposed) Crossword Clue The Crossword Solver found 20 answers to "completely (opposed)", 3 letters crossword clue. The Crossword Solver finds answers to classic crosswords and cryptic crossword puzzles. Enter the length or pattern for better results. Click the answer to find similar crossword clues . Dictionary Completely Opposed - Crossword Clue Answers - Crossword Solver The crossword clue Completely opposed with 9 letters was last seen on the March 23, 2015. We think the likely answer to this clue is DIAMETRIC. Below are all possible answers to this clue ordered by its rank. You can easily improve your search by specifying the number of letters in the answer. Completely Opposed To Crossword Clue, Puzzle and Solver - Crossword Leak The Crosswordleak.com system found 25 answers for completely opposed to crossword clue. Our system collect crossword clues from most populer crossword, cryptic puzzle, quick/small crossword that found in Daily Mail, Daily Telegraph, Daily Express, Daily Mirror, Herald-Sun, The Courier-Mail and others popular newspaper.
COMPLETELY crossword clue - All synonyms & answers - The Crossword Solver All solutions for "completely" 10 letters crossword answer - We have 2 clues, 105 answers & 119 synonyms from 3 to 17 letters. Solve your "completely" crossword puzzle fast & easy with the-crossword-solver.com Completely opposed - crossword puzzle clue Completely opposed is a crossword puzzle clue that we have spotted 2 times. There are no related clues (shown below). Referring crossword puzzle answers. DIAMETRIC; Likely related crossword puzzle clues. None so far; Recent usage in crossword puzzles: Pat Sajak Code Letter - Sept. 19, 2016 ... Adjective meaning completely opposed - crossword puzzle clues & answers ... Adjective meaning completely opposed. Today's crossword puzzle clue is a general knowledge one: Adjective meaning completely opposed. We will try to find the right answer to this particular crossword clue. Here are the possible solutions for "Adjective meaning completely opposed" clue. It was last seen in British general knowledge crossword. Completely opposed -- Crossword clue | Crossword Nexus Completely opposed -- Crossword clue | Crossword Nexus Potential answers for "Completely opposed" DIAMETRIC AMEN AVERSE TAKESBYSTORM ENEMIES AGAINST TOTALS SEVER FROMLEFTTORIGHT CRUSH What is this page? Need help with another clue? Try your search in the crossword dictionary! Clue: Pattern:
Opposed - crossword puzzle clue Opposed is a crossword puzzle clue that we have spotted over 20 times. There are related clues (shown below). There are related clues (shown below). Referring crossword puzzle answers
Completely Opposed Crossword Clue, Puzzle and Solver - Crossword Leak Crossword Clue The Crosswordleak.com system found 25 answers for completely opposed crossword clue. Our system collect crossword clues from most populer crossword, cryptic puzzle, quick/small crossword that found in Daily Mail, Daily Telegraph, Daily Express, Daily Mirror, Herald-Sun, The Courier-Mail and others popular newspaper.
Completely opposed - crossword puzzle clues & answers - Dan Word Completely opposed. Today's crossword puzzle clue is a general knowledge one: Completely opposed. We will try to find the right answer to this particular crossword clue. Here are the possible solutions for "Completely opposed" clue. It was last seen in Daily general knowledge crossword. We have 1 possible answer in our database.
Completely opposed to being in and left (8) - Crossword Genius Completely opposed to being in and left - Crossword Clue, Answer and Explanation Menu. ... Cryptic Crossword guide; Completely opposed to being in and left (8) I believe the answer is: outright I'm a little stuck... Click here to teach me more about this clue! ' completely ' is the definition. (outright means completely or totally) I don't ...
OPPOSED crossword clue - All synonyms & answers OPPOSED Crossword Clue & Answer 'OPPOSED' is a 7 letter Word starting with O and ending with D All Solutions for OPPOSED Synonyms, crossword answers and other related words for OPPOSED We hope that the following list of synonyms for the word opposed will help you to finish your crossword today.

























/https://tf-cmsv2-smithsonianmag-media.s3.amazonaws.com/filer/7c/5f/7c5f2be4-df48-40eb-a108-8b40cf5c96d6/dec2019_d09_prologue.jpg)

0 Response to "44 completely opposed crossword clue"
Post a Comment